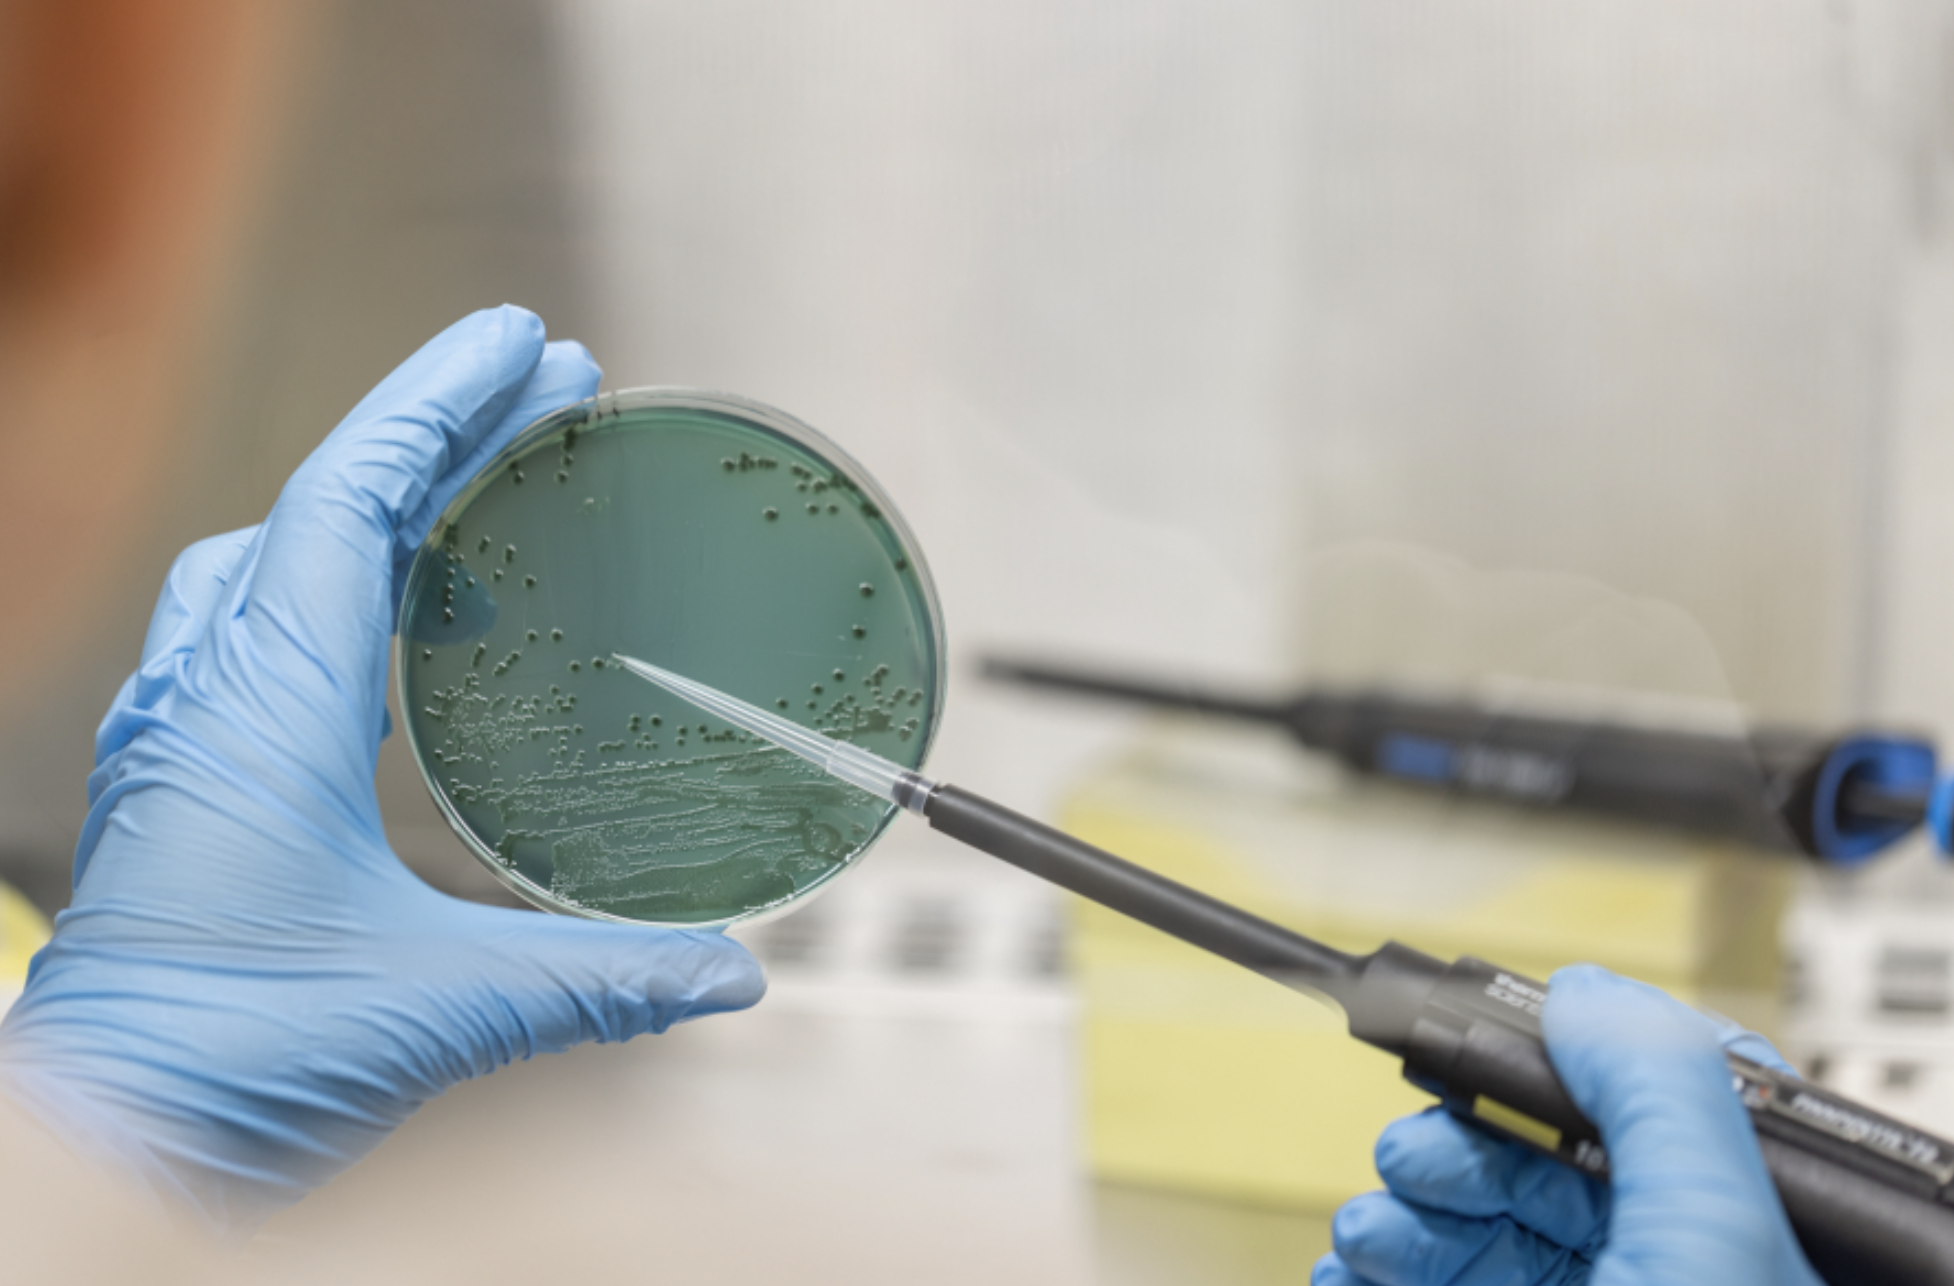
Noticia_8_09_25

Guants i taules de tallar, agents de contaminació creuada als sucs sense pasteuritzar
Descarregar PdfLes taules de tallar i els guants faciliten una transferència bacteriana més alta que els ganivets en l'elaboració de sucs sense pasteuritzar. Així ho assenyala un estudi realitzat per investigadores del departament de Tecnologia, Enginyeria i Ciència d'Aliments de la Universitat de Lleida (UdL) i Agrotecnio que acaba de publicar la revista Biology. El treball ha analitzat tres bacteris d'elevat risc per a la salut - Salmonella enterica, Escherichia coli O157:H7 i Listeria monocytogenes - en sucs de poma, maduixa i remolatxa. [Ampliar notícia]
Text: Comunicació Agrotecnio / Premsa UdL
MÉS INFORMACIÓ: